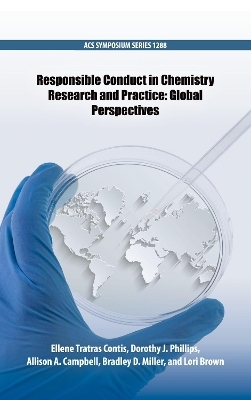
Responsible Conduct in Chemistry Research and Practice -

Responsible Conduct in Chemistry Research and Practice
Oxford University Press Inc (Verlag)
978-0-8412-3307-2 (ISBN)
- Keine Verlagsinformationen verfügbar
- Artikel merken
The development of Responsible Conduct in Chemistry Research and Practice: Global Perspectives was both inspired and informed by a symposium called "The Interface of Chemical and Biological Sciences International Disarmament Efforts" held in 2015 at the 249th ACS National Meeting & Exposition in Denver, Colorado, USA. Organized by the ACS Committee on International Activities (IAC) and with co-sponsorship from the ACS Division of Analytical Chemistry and
nominal support from the Organisation for the Prohibition of Chemical Weapons (OPCW), the event highlighted educational, policy and practice dimensions of advancing the peaceful application of chemistry worldwide.
In addition to the symposium speakers, the editors invited several other colleagues in the global chemistry enterprise to contribute papers furthering the editorial center of the present volume.
Dr. Ellene Tratras Contis, PhD, is Professor of Chemistry at Eastern Michigan University (EMU). At EMU she has served as Women's Studies Director, Associate Dean and Dean in the College of Arts and Sciences, Assistant Vice President for Academic Services, and Associate Vice President for Academic Affairs. She has done research in trace metal analysis of water and has traveled internationally for STEM education. Dr. Contis holds a Ph.D. in analytical chemistry from the University of Michigan, an M.S. degree in chemistry from the University of Pittsburgh, and a B.S. degree in chemistry from Youngstown State University. Dr. Dorothy Phillips, PhD, serves as a Director-at-Large for the ACS Board of Directors. She received her bachelor's degree in Chemistry from Vanderbilt University in 1967 and Ph.D. in biochemistry from the University of Cincinnati in 1974. She began her career with the Dow Chemical Company, but spent a majority of her career with the Waters Corporation, joining in 1984 and ending in 2013 as the Director of Strategic Marketing. Dr. Phillips has been involved with the ACS Northeastern Section since 1990, serving as Chair, Counselor, and, currently, Trustee. She has also served as chair for the ACS Analytical Chemistry Division. Dr. Allison A. Campbell, PhD, served as President of ACS in 2017. She works as Associate Laboratory Director of the Earth and Biological Sciences Directorate at Pacific Northwest National Laboratory, where her research has focused on biomaterials and understanding the role of proteins in biomineralization. Dr. Campbell holds a Ph.D. in Physical Chemistry from State University of New York at Buffalo and a B.A. from Gettysburg College. She was elected AAAS Fellow in 2013 and is a member of the National Academy of Sciences Chemical Sciences Roundtable and the Washington State Academy of Sciences. Bradley D. Miller, PhD, is Director, American Chemical Society (ACS) International Activities, Office of the Secretary and General Counsel, External Affairs and Communications. He has worked at ACS since 1999 developing programs to advance chemical sciences, engineering and education through exchange and collaboration. Dr. Miller serves on the U.S. National Commission for UNESCO. In 2006 he was recipient of an NSF Chemistry Discovery Corps Fellowship fostering U.S./Brazil collaboration in the chemistry. He has published ten articles and book chapters, and serves as co-editor of three published volumes of the ACS Book Series. He holds a Ph.D. from the University of Arizona. Ms. Lori Brown is an International Project Manager for ACS International Activities whose responsibilities include science and human rights, diplomatic outreach, and managing federal grants. She has been with ACS since 2013. Since 2016 she has managed the Global Chemists' Code of Ethics, which is funded by the U.S. Department of State's Chemical Security Program. Ms. Brown has a background in politics, and has worked for the U.S. House of Representatives and a lobbying firm. Prior to joining ACS, she served as an election observer in El Salvador. She holds a B.A. in History from the University of Evansville.
Preface
Global Efforts in Chemical Safety and Security
1. Chemical Disarmament in a Technologically Evolving World
2. Chemical Issues in Context: The Role of Intent in Nonproliferation & Disarmament
3. Emerging Chemical and Biological Technologies: Security & Policy Challenges
4. Education and Outreach: Key Elements To Promote the Responsible and Peaceful Uses of Chemistry
5. Finding Better Therapeutics for Chemical Poisonings
6. Chemical Safety and Security Challenges in Academic Institutions in Developing Countries
Ethics, Human Rights, and the Chemical Sciences
7. Exemplary Science and Human Rights Initiatives at ACS
8. The Global Chemists' Code of Ethics: International Cooperation for Increased Chemical Security and Safety
9. Scientific Societies for Human Rights: The American Chemical Society's Role in the AAAS Science and Human Rights Coalition
10. Chemists Contributing to Human Rights: Enhancing Research, Teaching and Global Impact
Responsible Conduct and Challenges in Chemistry
11. Responsible Conduct in Chemical Safety and Security Practices in South Asia
12. Responsible Conduct in Chemical Safety and Security Practices and Its Development in Malaysia
13. Responsible Conduct of Research and Challenges in the Middle East
14. Research in Africa: Responsible Conduct in Research Reporting and Challenges
15. Responsible Conduct and Challenges in North Africa
16. Responsible Conduct of Chemical Sciences Research and Challenges in Nigeria and West Africa
17. Responsible Conduct and Challenges in East Africa
Editors' Biographies
Author Index
Subject Index
| Erscheinungsdatum | 16.01.2019 |
|---|---|
| Reihe/Serie | ACS Symposium Series |
| Verlagsort | New York |
| Sprache | englisch |
| Maße | 157 x 233 mm |
| Gewicht | 572 g |
| Themenwelt | Naturwissenschaften ► Chemie ► Analytische Chemie |
| Wirtschaft ► Betriebswirtschaft / Management ► Unternehmensführung / Management | |
| ISBN-10 | 0-8412-3307-1 / 0841233071 |
| ISBN-13 | 978-0-8412-3307-2 / 9780841233072 |
| Zustand | Neuware |
| Informationen gemäß Produktsicherheitsverordnung (GPSR) | |
| Haben Sie eine Frage zum Produkt? |
aus dem Bereich


